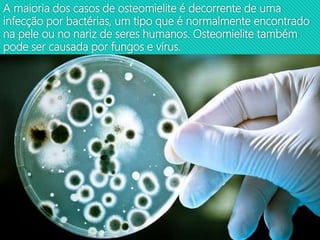
A maioria dos casos de osteomielite é decorrente de uma
infecção por bactérias, um tipo que é normalmente encontrado
na pele ou no nariz de seres humanos. Osteomielite também
pode ser causada por fungos e vírus.

A osteomielite é uma infecção óssea geralmente causada por bactérias que pode ocorrer quando os ossos são quebrados ou durante cirurgias, levando à dor, febre e inchaço. O tratamento envolve o uso de antibióticos e, em alguns casos, cirurgia para remover tecido ósseo infectado.